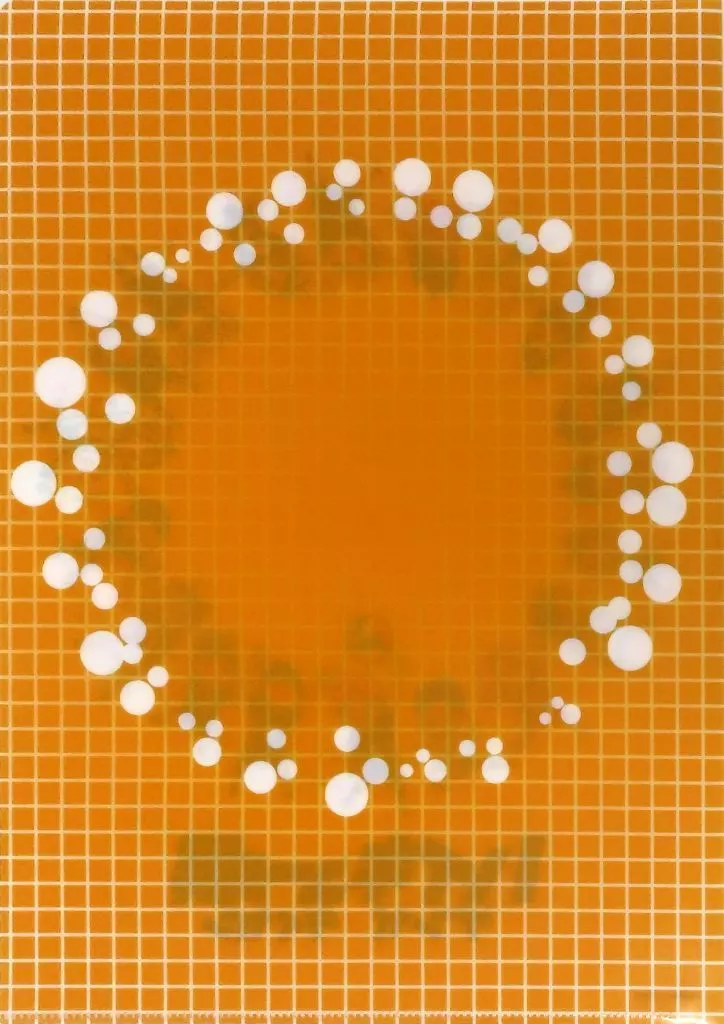

Set (Chibi Character / AH2-HQ) Limited A4 clear file "Haikyu!!! Exhibition Genga × Taikan"
※Tenga en cuenta que la información del producto está traducida por máquina, por lo que puede que no sea la traducción correcta.
407JPY
1,708JPY
0JPY
Precio de referencia
Aplica a la MEGA VENTA por Descuento por cantidadl
Número de control: 994160074
Fabricante: Shueisha
Descripción del producto ※Tenga en cuenta que la información del producto está traducida por máquina, por lo que puede que no sea la traducción correcta.
Este es el A4 Clear File 』 de "Haikyu!!! Exhibition Genga × Taikan" limitado al lugar de 『.
[Detalles del artículo]
Tamaño : A4